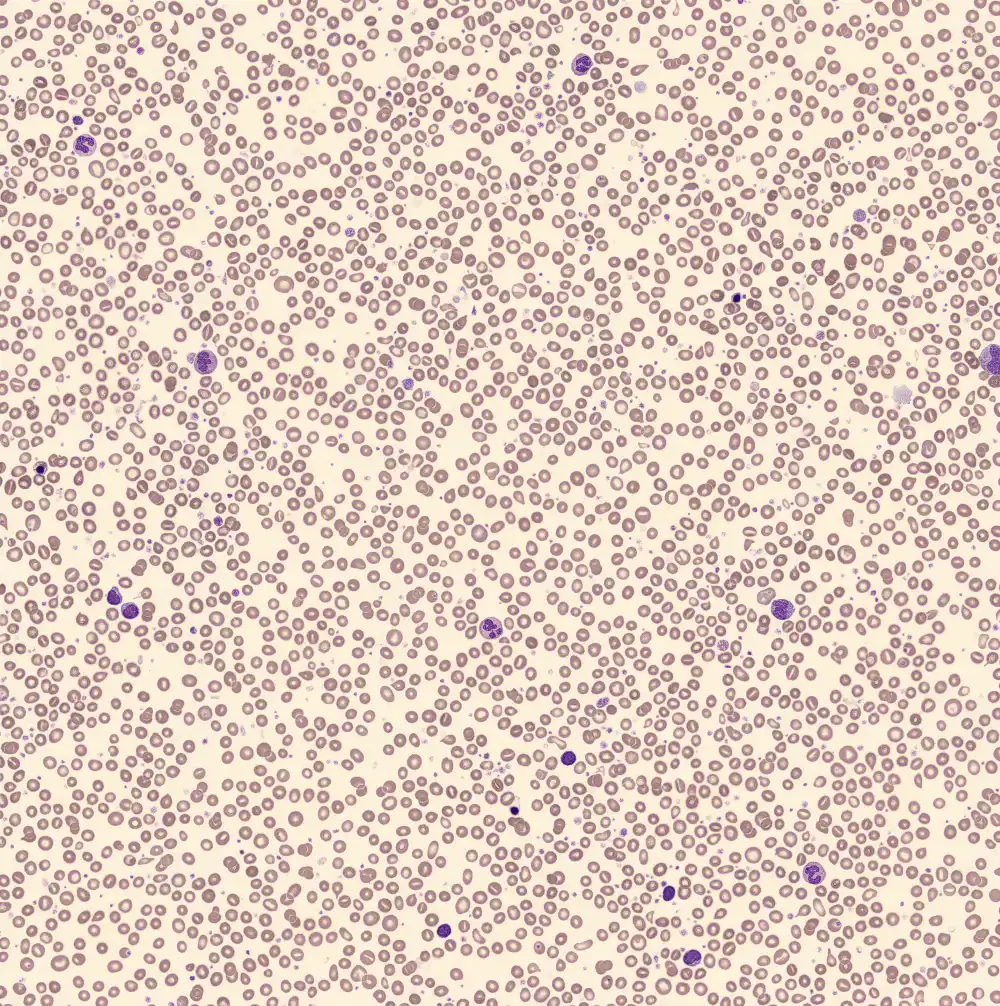

MFP - Lamelle 4
Myélofibrose primaire avec présence importante de micromégacaryocytes dans le sang périphérique. À première vue, les cellules rappellent les lymphocytes. Cependant, une partie d'entre elles présente un bord étroit de cytoplasme gris-bleu riche en granules violets. D'autres cellules morphologiquement similaires ne présentent que des protubérances cytoplasmiques très subtiles. En outre, les neutrophiles présentent des formes nucléaires aberrantes et une hypersegmentation.
Neutrophiles
Lymphocytes
Monocytes
Éosinophiles
Basophiles
Blastes
Micromégacaryocytes
XN Scatterplots
Sang périphérique
Blastes

Érythroblastes















Neutrophiles


















Micromégacaryocytes














































































































































































































